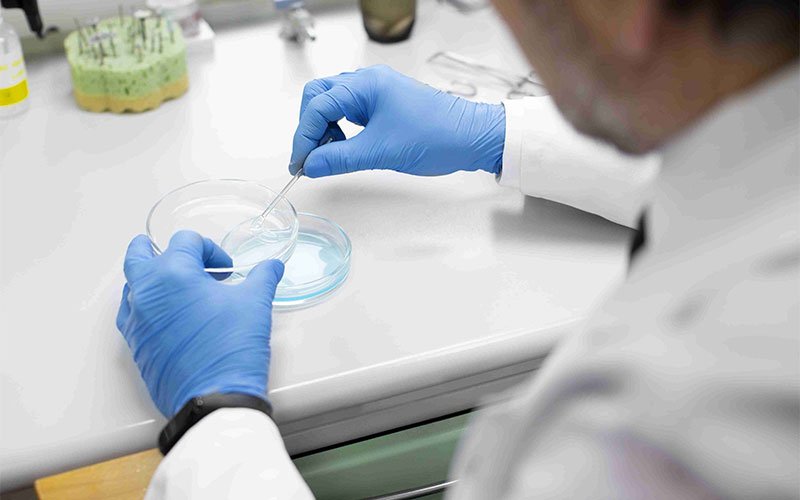

Cleaning Validation for Reusable Devices
Overview:
Reusable medical devices must be thoroughly cleaned before being disinfected or sterilized again.
Description:
This validation ensures that the cleaning process effectively removes blood, proteins, and other contaminants from medical devices.
Industries Served:
- Hospitals and surgical centers
- Dental equipment reprocesses
- Reusable instrument manufacturers
Purpose:
To ensure reprocessed devices are safe for reuse and meet health and safety standards.
Service FAQ
Do we need prescription for these testing?
Patholab’s Complete Care Geno identify DNA variant specific to an individual & provides report about detoxification. Hormone Insight can be useful at the Various stages of life.
What is the cost for these testing?
Patholab’s Complete Care Geno identify DNA variant specific to an individual & provides report about detoxification. Hormone Insight can be useful at the Various stages of life.
Do I have to come with empty stomach?
Patholab’s Complete Care Geno identify DNA variant specific to an individual & provides report about detoxification. Hormone Insight can be useful at the Various stages of life.
How much time it takes for report delivery?
Patholab’s Complete Care Geno identify DNA variant specific to an individual & provides report about detoxification. Hormone Insight can be useful at the Various stages of life.
What are the payment methods here?
Patholab’s Complete Care Geno identify DNA variant specific to an individual & provides report about detoxification. Hormone Insight can be useful at the Various stages of life.
Should I bring previous reports of mine?
Patholab’s Complete Care Geno identify DNA variant specific to an individual & provides report about detoxification. Hormone Insight can be useful at the Various stages of life.
How many tests are available for lipid profile?
Patholab’s Complete Care Geno identify DNA variant specific to an individual & provides report about detoxification. Hormone Insight can be useful at the Various stages of life.
